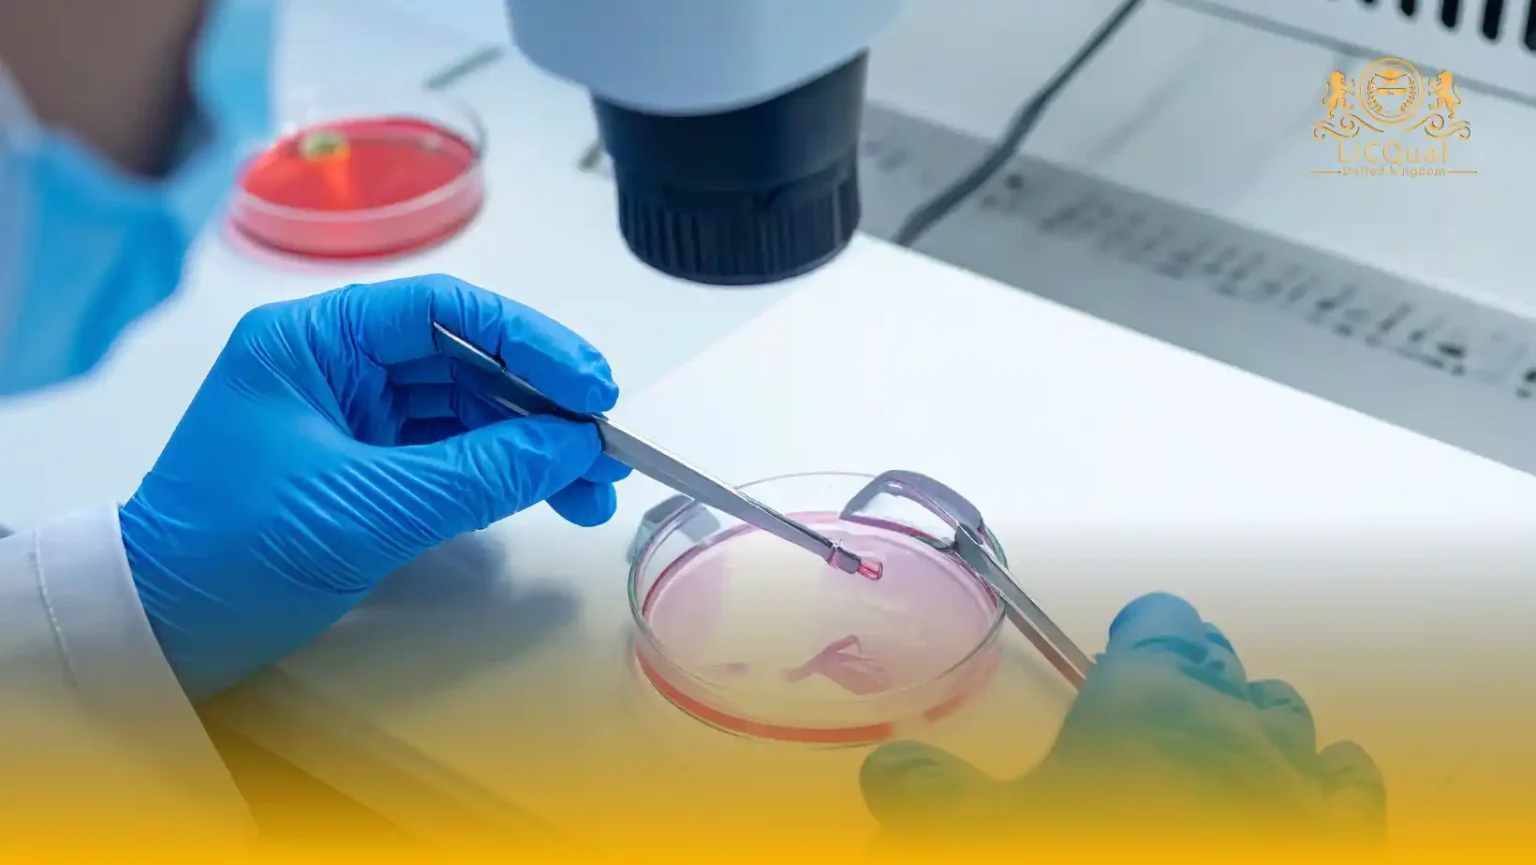
LICQual Level 3 Certificate in Reproductive Endocrinology and Infertility (Cert REI)

The LICQual Level 3 Certificate in Reproductive Endocrinology and Infertility (Cert REI) is a specialized qualification designed for healthcare professionals who want to advance their knowledge and skills in reproductive medicine. This Level 3 Reproductive Endocrinology and Infertility certification provides a clear pathway for doctors, nurses, and allied health practitioners to gain expertise in one of the most important and rapidly evolving areas of healthcare.
Reproductive endocrinology and infertility are critical fields that address the challenges of hormonal health, fertility, and advanced reproductive care. This reproductive endocrinology and infertility certificate program equips learners with the essential knowledge to understand complex hormonal systems, manage infertility cases, and apply evidence-based practices in clinical settings. By completing this accredited qualification, you will strengthen your ability to support patients with compassion, precision, and professional confidence.
Unlike general medical training, the Cert REI Reproductive Endocrinology and Infertility qualification focuses specifically on fertility and hormonal health. The course combines theoretical foundations with practical applications, ensuring that learners are prepared to meet real-world challenges in reproductive healthcare. It also supports continuing professional development (CPD), making it an excellent choice for professionals who want to enhance their portfolio and demonstrate commitment to lifelong learning.
This reproductive endocrinology and infertility training course is internationally recognized and aligned with professional standards, giving you a competitive edge in both local and global healthcare markets. Whether your goal is to advance within your current role, specialize in reproductive medicine, or expand your career opportunities, the LICQual Level 3 Certificate in Reproductive Endocrinology and Infertility (Cert REI) offers the credibility and skills you need.
By enrolling today, you can take the next step toward becoming a trusted specialist in reproductive endocrinology and infertility. With expert guidance, flexible learning, and a globally recognized qualification, this program is your gateway to professional growth and meaningful impact in healthcare.
Course Overview
Qualification Title
LICQual Level 3 Certificate in Reproductive Endocrinology and Infertility (Cert REI)
Total Units
6
Total Credits
24
GLH
120
Qualification #
LICQ2200865
Qualification Specification
To enroll in the LICQual Level 3 Certificate in Reproductive Endocrinology and Infertility (Cert REI) , applicants must meet the following criteria:
|
Qualification# |
Unit Title |
Credits |
GLH |
|---|---|---|---|
|
LICQ2200865-1 |
Foundations of Reproductive Endocrinology |
4 |
20 |
|
LICQ2200865-2 |
Infertility Assessment and Diagnosis |
4 |
20 |
|
LICQ2200865-3 |
Assisted Reproductive Technologies (ART) |
4 |
20 |
|
LICQ2200865-4 |
Management of Reproductive Disorders |
4 |
20 |
|
LICQ2200865-5 |
Patient Care and Counselling in Infertility |
4 |
20 |
|
LICQ2200865-6 |
Evidence-Based Practice and Professional Development |
4 |
20 |
By the end of this course, learners will be able to:
Unit 1: Foundations of Reproductive Endocrinology
- Explain the anatomy and physiology of the reproductive system.
- Describe hormonal regulation and its impact on fertility.
- Identify common endocrine disorders affecting reproductive health.
- Demonstrate understanding of hormonal cycles and reproductive function.
Unit 2: Infertility Assessment and Diagnosis
- Conduct comprehensive assessments for male and female infertility.
- Interpret diagnostic tests and hormonal profiles accurately.
- Evaluate clinical findings to identify infertility causes.
- Apply patient history-taking and risk assessment in infertility care.
Unit 3: Assisted Reproductive Technologies (ART)
- Explain the principles and procedures of IVF, ICSI, and other ART methods.
- Prepare patients effectively for assisted reproductive treatments.
- Demonstrate understanding of laboratory and clinical ART processes.
- Monitor and evaluate treatment outcomes to optimise patient care.
Unit 4: Management of Reproductive Disorders
- Identify appropriate treatment strategies for reproductive endocrinology disorders.
- Apply pharmacological and non-pharmacological interventions.
- Evaluate surgical options for reproductive health management.
- Collaborate with multidisciplinary teams for effective patient care.
Unit 5: Patient Care and Counselling in Infertility
- Communicate effectively with patients and families regarding reproductive health.
- Provide psychological support and address ethical considerations.
- Implement informed consent procedures and patient education strategies.
- Promote adherence to treatment plans and lifestyle recommendations.
Unit 6: Evidence-Based Practice and Professional Development
- Apply evidence-based practice in reproductive endocrinology and infertility care.
- Demonstrate commitment to continuous professional development (CPD) and reflective practice.
- Implement quality improvement and patient safety measures.
- Understand and comply with legal, ethical, and regulatory frameworks in reproductive medicine.
The LICQual Level 3 Certificate in Reproductive Endocrinology and Infertility (Cert REI) is designed for healthcare professionals who want to specialize in reproductive medicine and fertility care. This program is ideal for doctors, nurses, and allied health practitioners who aim to expand their expertise, gain CPD recognition, and improve patient outcomes in reproductive endocrinology and infertility. Whether you are seeking career advancement, international recognition, or specialized training, this course provides the skills and credibility to help you succeed.
1. Medical Doctors and Gynecologists
- Strengthen expertise in reproductive endocrinology and infertility management
- Gain a recognized Level 3 reproductive health qualification
- Learn evidence-based approaches to fertility treatment
- Enhance diagnostic and patient care skills in reproductive medicine
- Build credibility with an accredited Cert REI certification
2. Fertility Specialists and IVF Practitioners
- Deepen knowledge of hormonal and infertility disorders
- Improve patient outcomes with advanced fertility care techniques
- Stay updated with global standards in reproductive medicine
- Earn CPD credits while enhancing professional reputation
- Expand career opportunities in fertility clinics and hospitals
3. Nurses and Midwives
- Develop specialized skills in reproductive endocrinology and infertility support
- Gain confidence in assisting with fertility treatments and patient care
- Strengthen professional portfolio with a recognized certificate
- Learn patient-centered approaches to reproductive health
- Fulfill CPD requirements with accredited training
4. Allied Health Professionals
- Broaden scope of practice with reproductive endocrinology knowledge
- Support multidisciplinary teams in fertility and reproductive care
- Improve collaboration with doctors and fertility specialists
- Enhance employability with a specialized healthcare qualification
- Gain practical insights into infertility management
5. Healthcare Practitioners in Training
- Build a strong foundation in reproductive endocrinology and infertility
- Access structured learning aligned with professional standards
- Improve career prospects in reproductive and fertility medicine
- Gain early exposure to advanced reproductive healthcare practices
- Strengthen readiness for future specialization
6. International Healthcare Professionals
- Earn a globally recognized reproductive endocrinology qualification
- Align with UK and international healthcare standards
- Improve employability in global fertility and reproductive health sectors
- Access flexible learning suitable for international learners
- Gain credibility with an accredited Level 3 certificate
7. Professionals Seeking CPD and Career Growth
- Fulfill CPD requirements with accredited reproductive health training
- Demonstrate commitment to lifelong learning and specialization
- Strengthen career progression opportunities in healthcare
- Gain competitive advantage in reproductive medicine recruitment
- Build expertise in a high-demand medical specialty
Centres delivering the LICQual Level 3 Certificate in Reproductive Endocrinology and Infertility must adhere to the highest standards of education and training to ensure learners achieve success and develop professional competence. Centres should meet the following requirements:
- Qualified and Experienced Staff: Centres must employ trainers and assessors with recognised qualifications and practical expertise in reproductive endocrinology, infertility care, and clinical practice. Staff should be able to provide high-quality teaching, guidance, and assessment.
- Adequate Learning Facilities: Centres should provide suitable classrooms, clinical simulation labs, and practical training spaces that support both theoretical learning and hands-on experience.
- Access to Clinical Resources: Centres must have access to hospitals, fertility clinics, or clinical settings where learners can gain supervised practical experience. Essential medical equipment and instruments should be available for effective learning.
- Comprehensive Learning Materials: Centres should provide learners with access to course textbooks, e-resources, guidelines, and other relevant materials to support theoretical and practical understanding.
- Assessment and Learner Support Systems: Centres must implement robust assessment procedures, feedback mechanisms, and learner support services to facilitate academic progress and skill development.
- Health and Safety Compliance: Centres must comply with all applicable health and safety regulations, infection control protocols, and clinical governance standards to ensure a safe learning environment for learners and patients.
- Commitment to Quality: Centres should continuously monitor and improve teaching quality, ensuring alignment with LICQual standards and international best practices in reproductive medicine education.
By meeting these requirements, centres provide a professional, safe, and effective learning environment, enabling learners to successfully complete the LICQual Level 3 Certificate in Reproductive Endocrinology and Infertility and advance their careers in reproductive medicine.
Assessment and Verification
All units within this qualification are subject to internal assessment by the approved centre and external verification by LICQual. The qualification follows a criterion-referenced assessment approach, ensuring that learners meet all specified learning outcomes.
To achieve a ‘Pass’ in any unit, learners must provide valid, sufficient, and authentic evidence demonstrating their attainment of all learning outcomes and compliance with the prescribed assessment criteria. The Assessor is responsible for evaluating the evidence and determining whether the learner has successfully met the required standards.
Assessors must maintain a clear and comprehensive audit trail, documenting the basis for their assessment decisions to ensure transparency, consistency, and compliance with quality assurance requirements.